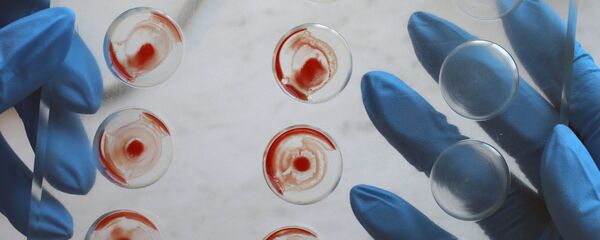
Работа станции переливания крови Работа станции переливания крови - Sputnik Южная Осетия

ЦХИНВАЛ, 27 июл — Sputnik. Подросток из американского штата Колорадо Джайден Роджерс страдает редким заболеванием соединительных тканей, из-за которого "превращается в камень", сообщает телеканал "Звезда".
По словам приемных родителей 12-летнего ребенка, пять лет назад на его бедре было обнаружено странное увеличивающееся уплотнение. Врачи поставили мальчику диагноз "синдром жесткой кожи" — болезнь, обнаруженная в начале 1970-х годов провоцирует отвердение кожи пациента, в результате чего он теряет способность двигаться. До этого случая было известно только о 40 пациентах в мире с данным синдромом.
На данный момент Роджерс уже почти не может двигаться и постоянно принимает сильные обезболивающие средства.
Семья ребенка, уже потратившая почти 700 тысяч долларов на различные медицинские процедуры, открыла сбор двух миллионов долларов, чтобы отправить мальчика на годовое лечение с использованием стволовых клеток в Европу.